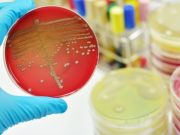
Invasores en el cuerpo

El nacimiento de los signos de interrogación
El desarrollo de la imprenta en el siglo XV creó la necesidad de contar con una puntuación estándar.Nuestro sistema de puntuación proviene del griego...
Curiosidades del clima
El arco iris y los vientos; dos fenómenos habituales pero no menos interesantes. Curiosidades del clima
¿Cómo se forma el arco iris?
En un día soleado es...
Rossini, el compositor musical que el mundo olvidó
A la edad de 37 años, Rossini había escrito 39 óperas; una de ellas, Guillermo Tell, se representó más de 500 veces en la Ópera de París, en vida del compositor. De repente, en 1829, dejó de escribir óperas, explicando que nadie podía cantarlas. Las piezas de Rossini requerían del bel canto, estilo basado en una excelente técnica vocal.
Invasores en el cuerpo
Los motivos ocultos detrás algunas enfermedades parasitarias y bacterianas.Estos son los invasores en el cuerpo más comunes, conózcalos:
¿Qué son la esquistosomiasis y el mal...
Migraciones
Caribúes y charranes recorren grandes distancias cada año.El azaroso viaje de los caribúes
En algunas regiones de América del Norte y del Ártico, las piedras...
Mundo animal: recordar para sobrevivir
Diferentes métodos animales para encontrar comida y casa.¿Qué trucos de la memoria posee cada especie?
Los cascanueces de América del Norte tienen tan buena memoria...
Cómo está formada la sangre
Los glóbulos rojos sirven como transporte, y los blancos como defensa.¿Cómo está formada la sangre?
En una sola gota de sangre hay más de 250...
Eadweard Muybridge y la fotografía de animales en movimiento
Stanford encargó a un fotógrafo inglés instalado en California, llamado Eadweard Muybridge, que tratara de captar con su cámara el movimiento de su caballo de carreras Occident.
Quetzalcóatl: ¿divinidad o mito?
Los vestigios más antiguos del culto al dios Quetzalcóatl se encontraron en Teotihuacán, en el Templo de la Serpiente Emplumada, también conocido como Ciudadela.¿Existió...
Ser vago ¡tiene beneficios!
Aunque no lo creas, aquellas que vemos como “malas costumbres” pueden ser positivas en diversos aspectos. Si ya tenés estos hábitos te vas a...